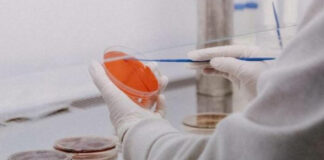
Descifran secuencia completa del virus de la viruela del mono Un grupo de investigadores del Instituto de Salud Carlos III (ISCIII) elaboraron el primer borrador de la secuencia.

Tag: Virus
Registran 470 casos probables de virus coxsackie en Puebla
El Gobierno del Estado, a través de la Secretaría de Salud, mantiene acciones de atención y vigilancia epidemiológica ante los brotes de virus coxsackie,...
Suman 201 casos de virus Coxsackie en Puebla durante 2025
De enero a la fecha, se han presentado en el estado 29 brotes de Coxsackie, dando un total de 201 casos, siendo Tlachichuca, Libres,...
Confirman 18 casos de virus Coxsackie en escuelas de Puebla
En Puebla, se han confirmado 18 casos activos del virus Coxsackie, detectados en dos planteles educativos: el Centro Escolar “Lázaro Cárdenas”, en Izúcar de...
Reportan cuarto caso de gripe aviar en EU
Las autoridades sanitarias de Estados Unidos reportaron el cuarto caso humano de gripe aviar en un trabajador agrícola en el estado de Colorado.
De acuerdo...
Lilia Cedillo recomienda estar prevenidos del virus de influenza aviar A...
Tras la aparición del primer caso de contagio por el virus de influenza aviar A H5N2 en México, la Rectora María Lilia Cedillo Ramírez...
Detienen en Tokio a hombre por crear virus informático con IA
La Policía de Tokio detuvo a un hombre de 25 años bajo sospecha de haber utilizado inteligencia artificial (IA) para crear un virus informático...
OMS valida nueva vacuna contra el dengue
La Organización Mundial de la Salud (OMS) anunció la validación de una nueva vacuna contra el dengue, la japonesa TAK-003, en un momento crítico...
Calentamiento global podría traer una nueva pandemia: expertos
Un grupo de científicos advirtieron que el deshielo por el calentamiento global podría traer una nueva pandemia.
Los expertos explicaron que una gran cantidad de...
Dengue suma 4 millones de contagios en el mundo; rompe récord
El dengue está propagándose en el hemisferio occidental a niveles sin precedentes en más de cuatro décadas, con más de 4 millones de casos...
México envía personal médico a Chile por brote de virus
La Secretaría de Salud explicó que esta acción busca proporcionar “ayuda solidaria” contra el brote del virus respiratorio sincitial en Chile.
OMS declara “listos” los ensayos de vacunas contra virus de Marburgo
La Organización Mundial de la Salud (OMS) declaró que ya "están listos" los protocolos de los ensayos con vacunas contra el virus de Marburgo
Salud reporta tres decesos por Covid-19 en Puebla
La Secretaría de Salud refirió que hay mil 507 casos activos, entre ambulatorios y hospitalizados, distribuidos en 55 municipios.
¿Palomas zombies? Silencioso virus afecta a aves de Reino Unido
El virus somete, principalmente a las palomas, a síntomas neurológicos nada propios de su especie como se ve en videos de redes sociales.
Nuevo León: detectan nueva cepa de gripe aviar en granja
En Nuevo León se detectó una nueva cepa de gripe aviar en una granja avícola luego de un estudio patológico por parte de la SENASICA.
América, epicentro de viruela del mono: OPS
Los países de América son “el epicentro” de una emergencia sanitaria a nivel mundial por viruela del mono.
Misterioso virus mata a decenas de perros en Michigan
Un misterioso virus infectó y mató decenas de perros en Michigan, así lo dio a conocer el periódico Clear County Cleaver.
Viruela del mono: 386 casos confirmados en México
Las cifras se incrementaron en un 53.8% con relación a la semana del 15 al 21 de agosto de 2022, con 252 portadores del Viruela del Mono.
¿Qué es la gripe del tomate? Detectan nuevo virus en India
Aquí te contamos sobre la nueva enfermedad llamada “gripe del tomate”, la cual ha infectado a decenas de niños en India.
Vacuna bivalente contra COVID es autorizada en UK
La vacuna bivalente también aumenta los anticuerpos contra las demás variantes existentes de Sars-Cov-2 en un prueba de 437 personas.
Descifran secuencia completa del virus de la viruela del mono
Un grupo de investigadores del Instituto de Salud Carlos III (ISCIII) elaboraron el primer borrador de la secuencia.